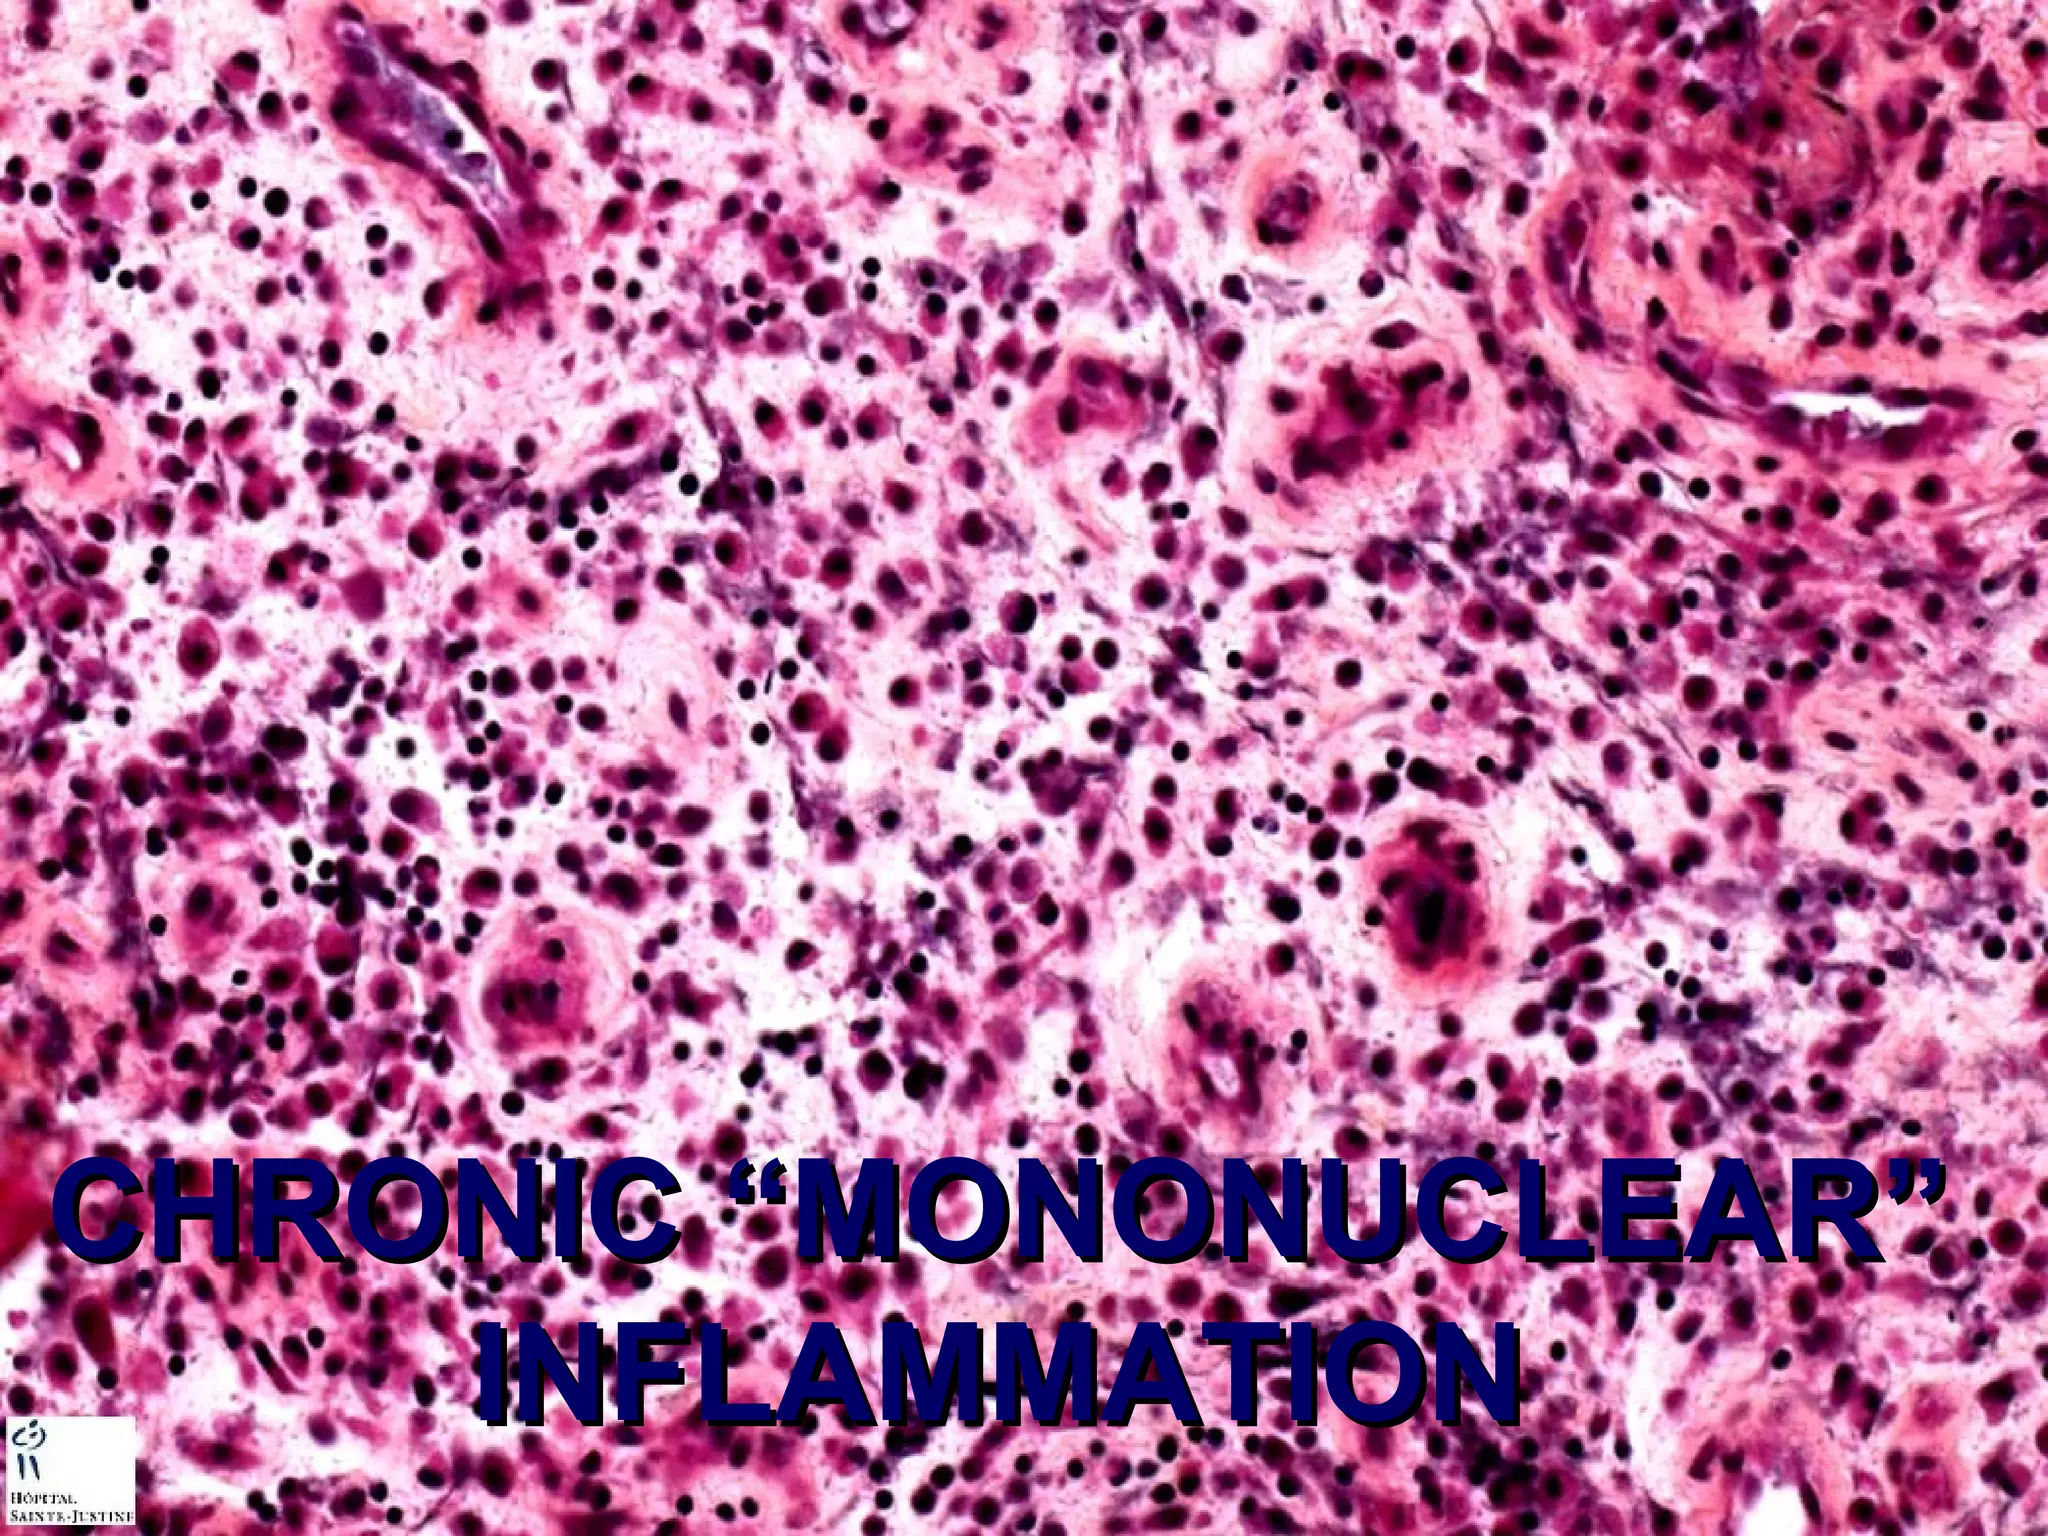
CCHHRROONNIICC ““MMOONNOONNUUCCLLEEAARR”” 
IINNFFLLAAMMMMAATTIIOONN
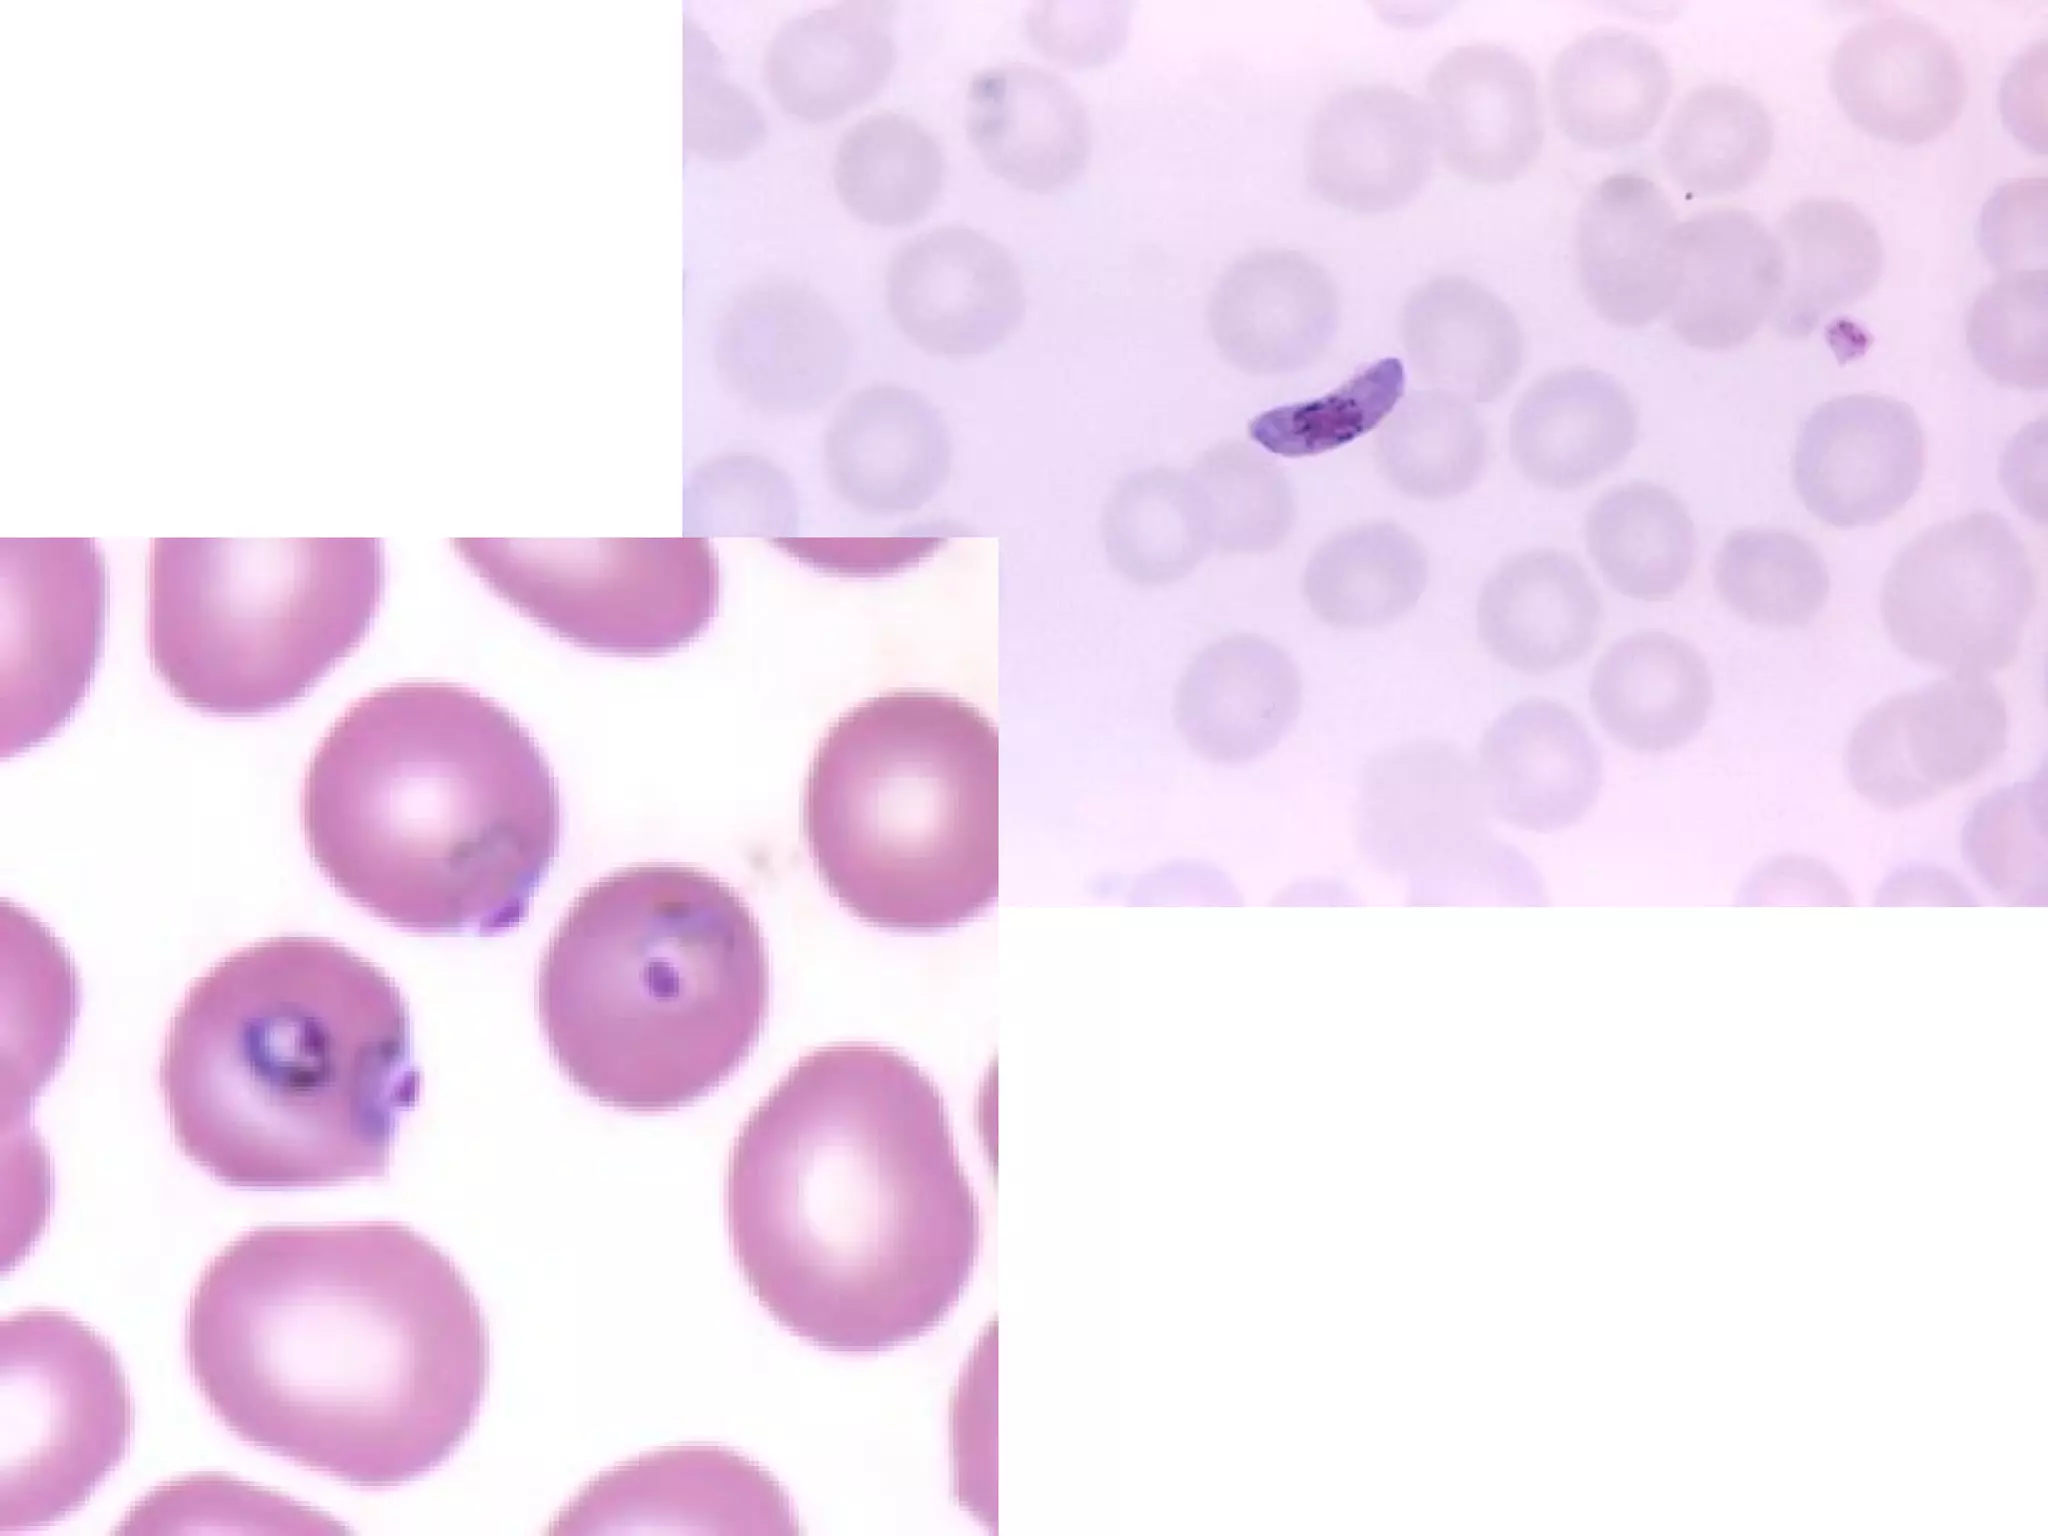

This document summarizes various infectious agents including prions, viruses, bacteria, fungi, parasites, and arthropods. It describes their characteristics, categories, habitats, life cycles, and examples of diseases they cause in humans. Key points covered include the structures and genomes of viruses, gram staining and shapes of bacteria, obligate intracellular nature of chlamydiae, rickettsiae and mycoplasmas, types of fungi and parasites, and examples of diseases caused by different pathogens.


















![Chlamydiae
Rickettsiae
Mycoplasmas
• Like Bacteria, but…..
–NO cell wall (mycoplasma [MANY
pneumonias])
–NO ATP (chlamydia [STD, worldwide
blindness])
–NO life outside a cell (obligate
intracellular, rickettsiae [RMSF])](https://image.slidesharecdn.com/8-infectious-140902100339-phpapp01/75/8-infectious-19-2048.jpg)





![HELMINTHS
(ROUND[nematode]), TAPE[cestode])
•Roundworms, Tapeworms
• Complex Life Cycles: sexual, asexual
• ROUNDWORMS (nematodes):
ASCARIS, TOXOCARA (VLM),
STRONGYLOIDES, ENTEROBIUS
• TAPE(FLAT)WORMS (cestodes):
TAENIA (solium vs. saginata),
DIPHYLLOBOTHRIUM, Hymenolepsis](https://image.slidesharecdn.com/8-infectious-140902100339-phpapp01/75/8-infectious-25-2048.jpg)